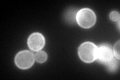
YMR058W
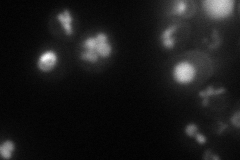
YMR058W

View description
Ferro-O2-oxidoreductase required for high-affinity iron uptake and involved in mediating resistance to copper ion toxicity, belongs to class of integral membrane multicopper oxidases
Localization:
Intensity:
Fold change:
Significance:
-
C’ GFP library in SD
cell periphery212.61 -
N' NOP1pr-GFP in SD

ER,vacuole104.577 -
N' TEF2pr-mCherry in SD
vacuole58.3326 -
N' NATIVEpr-GFP in SD

ER,vacuole133.132 -
N' TEF2pr-VC and Cyto-VN in SD

#N/A0 -
C’ GFP library in SD+DTT

cell periphery57.580.27Yes -
C’ GFP library in SD+H2O2

cell periphery234.991.1No -
C’ GFP library in Starvation Media

vacuoleN/AN/AYes -
C’ GFP library on the background of Pup2-DaMP

cell periphery -
C’ GFP library on the background of CCT mutant

cell periphery145.6770.685156Yes
